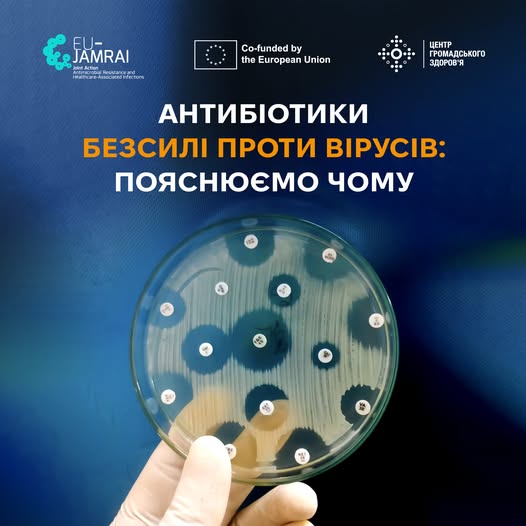

В Україні розпочався сезон ГРВІ — час, коли люди частіше хворіють на грип, COVID-19 та інші респіраторні вірусні захворювання. Водночас досі поширене хибне уявлення, що їх можна швидко й ефективно вилікувати антибіотиками навіть без призначення лікаря.
Центр громадського здоров’я пояснює, чому це не так і які можливі наслідки


Гострі респіраторні вірусні інфекції спричиняють ВІРУСИ, а антибіотики діють виключно на БАКТЕРІЇ. Лікування ГРВІ антибіотиками не дасть очікуваного результату, навпаки — може спричинити шлунково-кишкові розлади, порушення роботи нирок і печінки.

Прийом антибіотиків, коли до цього немає показань, може знизити їхню ефективність у майбутньому. Хвороботворні бактерії з часом адаптуються до антибіотиків — розвивається антибіотикорезистентність. Через це лікарям тяжче успішно лікувати інфекційні хвороби, у тому числі небезпечні (бактеріальна пневмонія, туберкульоз, сепсис). Антибіотикорезистентність створює додаткове навантаження на медичну систему в Україні під час війни.

У кишківнику людини може порушитися здоровий баланс бактерій. Це може спричинити розлади травлення й ослаблення імунітету.

Від ГРВІ не завжди потрібні ліки. За легкої застуди може бути достатньо відпочивати і пити багато води.

Тільки лікар може призначати антибіотики й лише у разі підтвердження або обґрунтованої підозри на бактеріальну природу інфекції.
Чотири прості й перевірені поради, як уберегти від ГРВІ себе та близьких:

Вакцинуйтеся від грипу раз на сезон. Щеплення проти грипу можна зробити, звернувшись до свого сімейного лікаря та придбавши вакцину в аптеці.

Вакцинуйтеся проти COVID-19. Щоб отримати щеплення, зверніться до свого сімейного лікаря або в найближчий заклад охорони здоров’я.

Дотримуйтеся правил особистої гігієни:

мийте руки з милом щонайменше 30 секунд;

використовуйте антисептики зі вмістом спирту не менше 70%;

коли кашляєте або чхаєте, прикривайте рот і ніс згином ліктя або серветкою;

не чіпайте брудними руками лиця.

Зміцнюйте імунітет:

дотримуйтеся режиму здорового харчування;

багато пийте: воду, трав’яні чаї, натуральні соки;

регулярно займайтеся руховою активністю;

лягайте спати завжди в один час і спіть не менше 7–8 годин на добу;

мінімізуйте стрес за змоги.